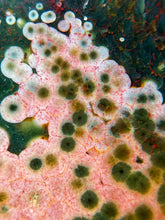
Load image into Gallery viewer, Kabamby Ocean Jasper Palmstone A

Listing is for pictured crystal. Please note any minor imperfections that may be present due to being a natural crystal.
Please read policies before placing your order - all sales final! Shipping insurance for your order is available at checkout via Route shipping insurance - as a small business we do not offer refunds on lost or damaged packages, which is why we offer this affordable third party protection option for orders of any size 🤍